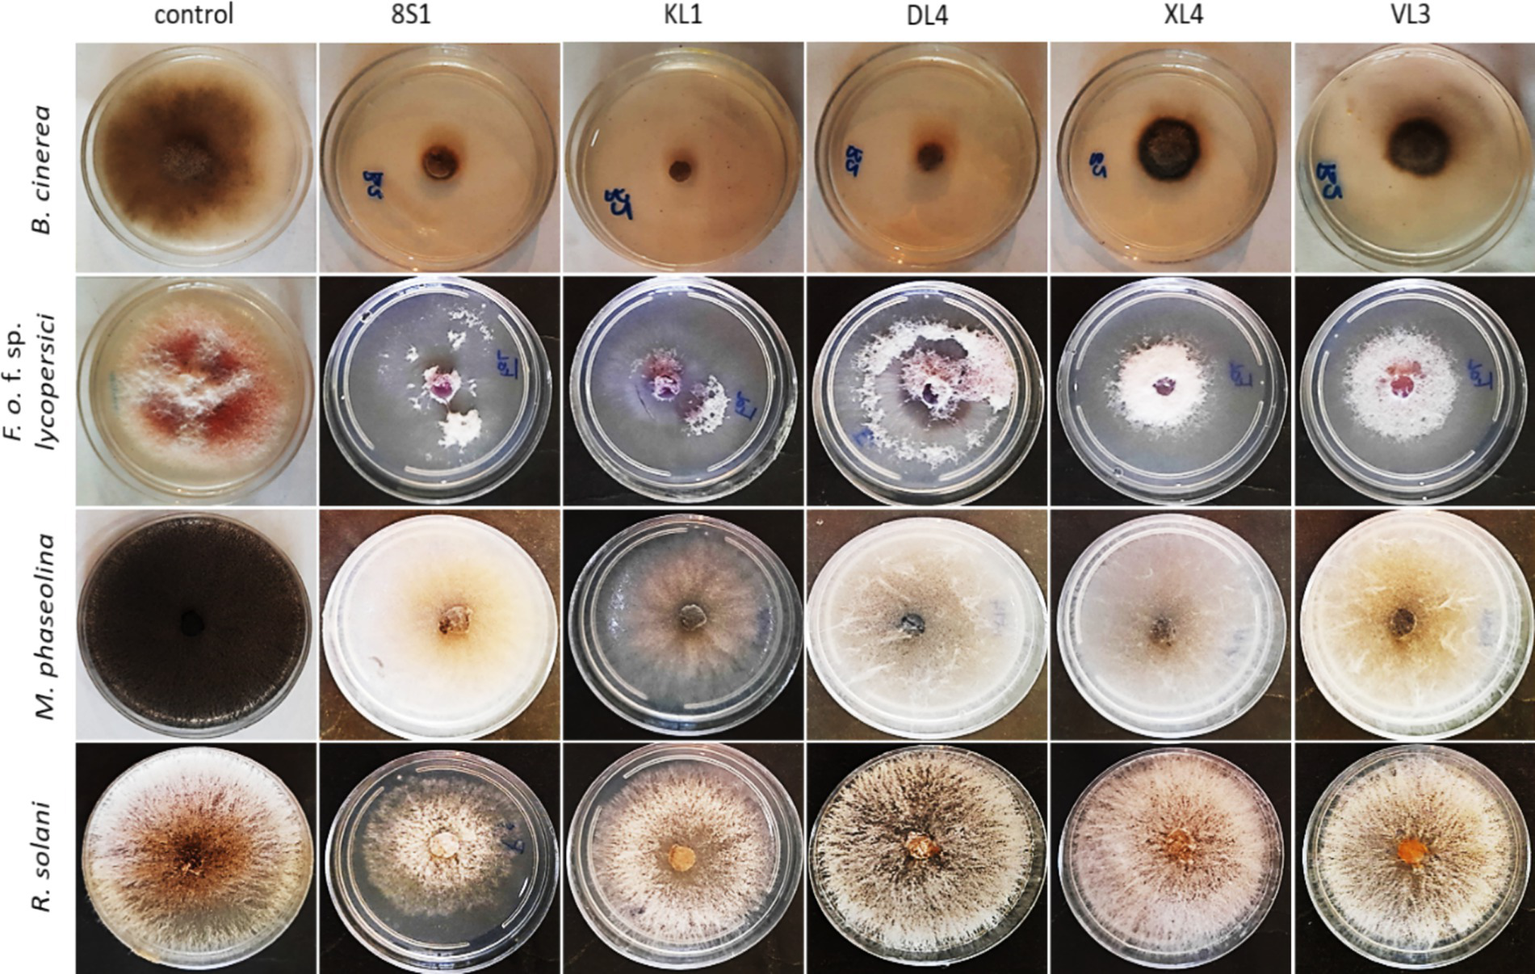

Abstract
Endophytic fungi colonize plants without causing symptoms, throughout or at least a significant part of their life cycle, forming a plant-fungal association. In this study, endophytic fungi were isolated from Eucalyptus camaldulensis trees, and their antifungal activity was evaluated against four significant plant pathogens namely Botrytis cinerea, Fusarium oxysporum f. sp. lycopersici, Macrophomina phaseolina, and Rhizoctonia solani. For this aim, 754 fungal isolates were obtained from 44 healthy fruit, leaf, and branch samples collected from five provinces of Iran. Subsequently, 27 fungal genera were identified based on morphological characteristics and molecular data of ITS region, with Neofusicoccum, Cladosporium, Didymosphaeria, and Chaetomium being the most commonly found genera. Based on the morphological characteristics, 170 isolates were chosen and their antifungal activities were assessed against the aforementioned pathogens in vitro through dual culture and volatile organic compounds (VOCs) tests. Based on the results, five isolates comprising Trichoderma sp. KL1, Trichoderma sp. 8S1, Chaetomium sp. DL4, Phaeophleospora sp. XL4, and Pseudosydowia sp. VL3 were selected for further investigation, which included examining their chitinase and cellulase secretion capabilities as potential antagonism mechanisms and their ability to solubilize phosphate as a growth-promoting mechanism. Furthermore, the antifungal activity of the selected isolates was evaluated against plant pathogens on tomato plants under greenhouse conditions. Their impact on plant growth parameters was also assessed. In vitro and greenhouse experiments demonstrated that each selected isolate exhibited varying levels of control against different pathogens. Among the isolates, Trichoderma sp. isolates KL1 and 8S1 consistently exhibited the strongest inhibition of disease severity for all four pathogens under greenhouse conditions. Lastly, the selected isolates were identified as Trichoderma longibrachiatum KL1, T. longibrachiatum 8S1, Chaetomium globosum DL4, Phaeophleospora eucalypticola XL4, and Pseudosydowia eucalypti VL3 based on their morphological features and molecular data of the ITS1-5.8S-ITS2 and tef-1α genomic regions.
1 Introduction
The widespread occurrence of plant diseases has resulted in substantial economic losses and reduced plant yield and production rates globally, making them a major agricultural concern (Hardoim et al., 2015). Tomato (Solanum lycopersicum L.), belonging to the Solanaceae family, ranks as the world’s second most extensively cultivated vegetable crop (Panno et al., 2021). The cultivation of both fresh market and processed tomatoes is hindered by various diseases caused by fungi, bacteria, phytoplasmas, viruses, and viroids. Among these pathogens, Alternaria solani, Botrytis cinerea, Fusarium oxysporum, and Sclerotinia sclerotiorum stand out as the most critical fungal adversaries (Gilardi et al., 2021). Disease management strategies often rely heavily on the frequent application of fungicides, which can be both expensive and time-consuming (Wenneker and Thomma, 2020). Given the importance of environmental sustainability, public health, and the development of resistance to pathogens, the use of chemical fungicides should be carefully regulated (Latz et al., 2018). Due to these considerations, there is a growing demand for alternative disease management methods. These methods should provide environmentally friendly and economically viable solutions to combat plant diseases (Hardoim et al., 2015; Latz et al., 2018). In addition to selecting disease-resistant plants and implementing other management practices, biocontrol using beneficial microorganisms is increasingly recognized as a crucial component of comprehensive disease management strategies. Recent years have witnessed a heightened effort to identify and utilize these microorganisms (Hardoim et al., 2015; Wani et al., 2015). Furthermore, endophytes represent a promising source of biocontrol agents, as they are well-adapted to colonize and survive within plants without causing significant harm (Zhang et al., 2018; Ebrahimi et al., 2022).
Fungal endophytes colonize inner plant tissues without causing symptoms of disease, thus providing benefits to the host plant while also benefiting from this interaction (Yan et al., 2019). These microorganisms exhibit a broad host range, colonizing diverse plant species and inhabiting all plant organs, encompassing roots, stems, leaves, flowers, fruits, and seeds (Ling et al., 2024). Numerous studies highlight the positive effects of endophytic colonization, including direct benefits like nutrient acquisition and phytohormone production and indirect benefits such as induced resistance, antibiotic and secondary metabolite production, siderophore production, and protection against abiotic and biotic stresses (Baron and Rigobelo, 2022). Endophytic fungi bio-inhibit pathogens through various mechanisms, comprising hyperparasitism, competition, antibiosis, and induced resistance, which can weaken or eliminate them (Latz et al., 2018). These fungi are capable of producing a wide array of chemically diverse secondary metabolites, which exhibit antimicrobial, antifungal, antiparasitic, anticancer, and antiviral activities (Attia et al., 2022). Furthermore, these microorganisms are crucial for their host plants, performing vital functions such as boosting growth and development, augmenting biomass, aiding in water and nutrient uptake, enhancing resistance to different stresses, and facilitating the accumulation of secondary metabolites that confer immunity, allelopathic resistance, and carbon sequestration (Jia et al., 2020). Among the secondary metabolites produced by endophytic fungi are steroids, alkaloids, phenols, isocoumarins, xanthones, quinones, and terpenoids (Manganyi and Ateba, 2020). These fungi can provide benefits through their action as biological control agents and the activation of plant defense responses to biotic stresses (Fontana et al., 2021). Interestingly, endophytic fungi exhibit more diverse metabolic profiles than soil fungi (Hashem et al., 2023). This suggests that endophytes are more likely to provide a consistent and reliable control effect, making them ideal candidates for biocontrol applications (Bardin et al., 2015).
The genus Eucalyptus (Myrtaceae), native to Australia and encompassing over 700 species, is globally cultivated for its medicinal, oil, paper, pulp, charcoal, gum, energy, timber, furniture, housing, and other esthetic properties (Labate et al., 2009; Batish et al., 2008). Essential oils derived from various Eucalyptus species are extensively utilized across the pharmaceutical, cosmetic, food, and industrial sectors, owing to their abundant chemical makeup and antimicrobial efficacy. Also, essential oils of various Eucalyptus species are noted for their diaphoretic, disinfectant, antimalarial, antiseptic, analgesic, anti-inflammatory, antimicrobial, antifungal, antibacterial, and antiviral properties, expectorant, and antioxidant attributes (Marzoug et al., 2011; Ahmad et al., 2023). The Eucalyptus oil is a complex mixture of a variety of monoterpenes and sesquiterpenes, and aromatic phenols, oxides, ethers, alcohols, esters, aldehydes and ketones which possess toxicity against a wide range of microbes including bacteria and fungi (both soil-borne and post-harvest pathogens), insects and nematodes (Batish et al., 2008). Interestingly, fungal endophytes are prolific producers of compounds with practical applications in agrochemicals or medicine such as antiviral, antimicrobial, anticancer, immunosuppressive, antidiabetic, antioxidant, etc. which may be similar to those produced by their host plants (Fadiji and Babalola, 2020).
Various studies have been conducted to evaluate the Eucalyptus endophytic fungi. Mao et al. (2021) obtained 80 endophytic fungal isolates from E. exserta, identifying 13 genera: Penicillium Link, Chaetomium Kunze, Cladosporium Link, Phyllosticta Pers., Eutypella (Nitschke) Sacc., Purpureocillium Luangsa-ard, Houbraken and Samson, Gongronella Ribaldi, Talaromyces C.R. Benj., Pestalotiopsis Steyaert, Fusarium Link, Lophiostoma Ces. and De Not., Scedosporium Sacc. ex Castell. and Chalm., and Pseudallescheria Negr. and I. Fisch.
Despite extensive research on endophytic fungi in various plant species, their association with Eucalyptus trees in Iran as well as their antagonistic effects against plant pathogens remain poorly understood. This investigation aimed to isolate and characterize endophytic fungi from E. camaldulensis Dehnh. in some provinces of Iran, and evaluate their potential to control some important plant pathogens, including B. cinerea, F. oxysporum f. sp. lycopersici race 3, Macrophomina phaseolina, and Rhizoctonia solani in vitro and in greenhouse.
2 Materials and methods
2.1 Sample collection and endophytic fungi isolation
Healthy samples of E. camaldulensis, including leaves, branches, and fruits, were collected from Tehran, Alborz, Qom, Isfahan, and Mazandaran provinces of Iran, during autumn of 2022. After cleaning with tap water, samples underwent sterilization using a method established by Strobel and Daisy (2003), which involved treatments with ethanol, sodium hypochlorite, and sterile water. For branches, the outer layer was removed under sterile conditions. Samples were cut and incubated on water agar medium at 25°C for 2 to 4 weeks. Emerging fungi were transferred onto potato dextrose agar (PDA) for purification. Obtained fungal isolates were identified at the genus level based on their morphological characteristics using authentic mycological monographs and literatures prepared by Simmons (2007), Ellis (1971, 1976), Klich and Pitt (1988), Klich (2002), Sivanesan (1987), and Watanabe (2002). Purified isolates were preserved at 4°C, and archived at the Fungal Collection of Agricultural Biotechnology Research Institute in Karaj, Iran.
2.2 Biocontrol experiments in vitro
2.2.1 Dual culture method
Initially, the antifungal activity of 170 endophytic isolates was evaluated against four phytopathogenic fungi including B. cinerea (Jalali et al., 2021), F. oxysporum f.sp. lycopersici race 3, M. phaseolina (Shirali, 2017), and R. solani by the triple spot culture test. Subsequently, antagonistic isolates were selected for a dual culture test as described by Dennis and Webster (1971). The plates were incubated at 25°C for 5 days. The growth inhibition is calculated using the formula GI% = [(a − b)/a] × 100, where ‘GI’ is the percentage of growth inhibition (GI), ‘a’ is the pathogen’s colony diameter in control, and ‘b’ is the pathogen’s colony diameter in dual culture (Etebarian et al., 2005). The experiment was conducted with three replicates and repeated twice.
2.2.2 Volatile organic compound-mediated interactions
Further investigation focused on VOCs emitted by endophytes, according to Lillbro (2005). This involved growing both endophytes and pathogens on PDA, layering the pathogen-containing plates atop those with endophytes, sealing them with Parafilm to trap VOCs, and incubating at 25°C. Furthermore, control treatments consisted of plates with pathogens placed between uninoculated PDA plates. After 1 week, pathogen growth was assessed, and the abovementioned formula was applied to quantify reductions. The experiment was carried out with three replicates and repeated twice.
2.2.3 Chitinase activity
The method for assessing chitinase production followed Hsu and Lockwood (1975). Endophytic isolates were cultured on chitin agar (0.4% colloidal chitin +1.5% agar, pH 7.2), prepared according to Berger and Reynold (1958). After 5 days at 25°C, chitinase activity was indicated by a clear zone around the colonies, quantified by comparing the diameter of the clear zone to the colony diameter. The experiment was carried out with three replicates and repeated twice.
2.2.4 Cellulase activity
Fungal isolates were grown on a CMC agar medium (containing KH2PO4, CaCl2, FeSO4·7H2O, CMC, and agar, pH 7.2) at 25°C for 7 days. For evaluating the cellulase activity, the medium was first stained with Congo Red solution for 20 min, then rinsed with NaCl for 15 min. Cellulase activity was calculated as the ratio of clear zone diameter to colony diameter, aligning with Majidi et al. (2011) method. The experiment was performed in triplicate and repeated twice.
2.2.5 Phosphate solubilization
Endophytic isolates were tested for their ability to solubilize phosphate by culturing them on Sperber medium (insoluble phosphate-enriched, pH 7.2) at 25°C for 7 days. The solubilization index was calculated by comparing the diameter of the clear zone around each colony to the colony’s diameter, following Sperber (1958) method. The experiment was conducted in triplicate and repeated twice.
2.3 Greenhouse experiments
2.3.1 Plant cultivation
Tomato (cv. Early Urbana Y) seeds were sterilized in a 0.5% sodium hypochlorite solution (with 5% active chlorine) for 5 min, followed by 3 sterile water rinses, as per Herrera-Téllez et al. (2019). Seeds were germinated in a sterile perlite-coco peat mixture in seedling trays, and kept in a greenhouse for 3 weeks. Plants were grown in 14-inch plastic pots filled with a custom soil mix of sterilized field soil, coco peat, and sand, autoclaved 3 times to ensure sterility. Two seedlings per pot were planted to provide optimal growing conditions.
2.3.2 Biocontrol of grey mold disease
An initial pathogenicity test was conducted to assess the pathogenicity of B. cinerea B2, and optimize greenhouse conditions. For the biocontrol assay, tomato plants were inoculated with B. cinerea at a concentration of 105 conidia/ml using a spray method, targeting the aerial parts of the plants. This inoculation occurred 1 week after the plants had been treated with endophytic fungi at 108 spores/ml, also applied with the same method. Control treatment received sterile distilled water. Plants were treated at the 4–6 leaf stage. After inoculation, each pot was sealed with a plastic bag to maintain 100% humidity for 48 h, then moved to a greenhouse with >80% humidity and 20 ± 2°C. Observations were daily made to track symptom development. Disease severity was measured by quantifying affected areas and calculating infection percentages. The disease inhibition rate of each antagonist was compared to the control to determine efficacy (Ebrahimi et al., 2023). Three pots each containing two seedlings were considered for each treatment and the experiment was repeated twice.
2.3.3 Biocontrol of Fusarium wilt
An initial pathogenicity test was performed to evaluate the virulence of F. oxysporum f. sp. lycopersici race 3 (FOL). For biocontrol test, tomato seedlings were inoculated with fungal endophytes using a 30 min root-dip method at a concentration of 108 conidia/ml. One week later, seedlings were dipped in a FOL suspension of 5 × 107 conidia/ml (Abbasi et al., 2019). Control seedlings were dipped in sterile distilled water. Seedlings were watered daily, kept at 28 ± 2°C, and exposed to 16 h of light and 8 h of darkness. Disease severity was monitored daily and scored using a scale from 0 to 5, where 0% indicates no symptoms, and 100% indicates death (Marlatt et al., 1996). Each treatment involved three pots, each with two seedlings, and the entire experiment was duplicated.
2.3.4 Biocontrol of charcoal rot disease
An initial pathogenicity test confirmed the pathogenicity of M. phaseolina M14. Isolates of endophytic fungi and M. phaseolina were grown on PDA for 7 days, then transferred on autoclaved sand-corn meal medium in Erlenmeyer flasks and incubated at 25°C for endophytes and 30°C for M. phaseolina for 3 weeks (Etebarian et al., 2007). Inoculums were mixed with potting mix at a 10% ratio by weight for both endophytes and M. phaseolina, with a one-week interval before planting (Jimenez-Diaz et al., 1983). Two seeds per pot were sown in each pot. Plants were grown in a greenhouse at 30 ± 2°C. Symptoms were monitored daily, and disease severity was rated from 1 to 5 based on discoloration and microsclerotia visibility (Paris et al., 2006). For every treatment, three pots were utilized, and the experimental procedures were carried out twice.
2.3.5 Biocontrol of Rhizoctonia damping-off disease
Following the initial pathogenicity tests, fungal isolates’ inoculum was prepared by soaking corn seeds in distilled water, autoclaving them, and inoculating with R. solani 124 and endophytic isolates. All inoculums were incubated for 6 weeks at 25°C in darkness. As a control, autoclaved corn seeds were also incubated similarly. An autoclaved soil mixture (soil: perlite: peat moss, 3:1:1) was prepared and mixed with the inoculum (fungi-inoculated corn seeds, 8 g/kg soil). Tomato seedlings were planted in this inoculated soil 1 week after endophyte treatment, and the pots were incubated in a greenhouse with 40% humidity, 22 ± 2°C, and a 16 h light cycle. Watering was done daily, and symptoms were monitored daily. After 3 weeks, data were collected on lesion occurrence, and root rot ratings using a scale from 1 (no root rot) to 5 (pre-emergence damping-off and minimal roots) (Dorrance et al., 2003). In the setup for each treatment, 3 pots were prepared, each with 2 seedlings, and the experiment was conducted in duplicate.
2.3.6 Estimating plant growth parameters
After completing the experiments (3 weeks after inoculation), plant growth parameters including fresh and dry weight as well as plant height were evaluated. Fresh and dry weights were measured using an analytical balance, with plants dried at 60°C for 4 h before weighing. All measurements were recorded for 6 plants of each treatment with two independent repetitions.
2.4 Evaluation of endophytic isolate colonization
For this purpose, tomato plants treated with endophyte isolates were cleaned under tap water to remove soil. Plant material was then disinfected using the method described by Strobel and Daisy (2003). Fungi were cultured from leaves, stems, and roots onto WA medium, purified using the hyphal tip method. The presence of inoculated fungi was confirmed through their colonization of various plant parts. Fungal isolates were morphologically identified, following method used by Ebrahimi et al. (2022).
2.5 Statistical analysis
The experiments were conducted in a completely randomized design and complete randomized block design for in vitro and in greenhouse investigations, respectively. Statistical analysis was carried out using SAS software, version 9.0. Initially, it was verified that the data conformed to a normal distribution. Subsequently, the data underwent analysis of variance (ANOVA), followed by Duncan’s multiple range test (Steel and Torrie, 1980).
2.6 Molecular identification of endophytic fungi
Antagonistic endophytic fungi were identified based on morphological features on Oatmeal Agar (OA), Potato Carrot Agar (PCA), Malt Extract Agar (MEA), and PNA (Pine Needle Powder Agar) media, with emphasis on colony characteristics, mycelia structure, teleomorphic/anamorphic stages, and reproductive structures, using various monographs including Samuels (2006), Samuels et al. (2012), Crous et al. (2016), Thambugala et al. (2014), Prokhorov and Linnik (2011).
Selected isolates showing antagonism against pathogenic fungi were cultured on PDA under dark conditions at 25°C for 7 days. DNA was extracted using the CTAB method (Carter-House, 2020), and then amplified for ITS and tef-1α regions using ITS1/ITS4 (White et al., 1990), and EF1/EF2 primers (O'Donnell et al., 1998), following PCR conditions from Ebrahimi and Fotouhifar (2016). DNA sequencing was done at Noor Genetics Center, Tehran, Iran.
The sequences obtained were compared to related species using NCBI BLAST to confirm the taxonomy. Sequences were submitted to GenBank for public access. In the phylogenetic analyses, genomic region sequences of tef-1α and ITS from various species were aligned with corresponding reference sequences of related species, retrieved from GenBank (Supplementary Table S1), using ClustalW (Thompson et al., 1994). Subsequently, Maximum Likelihood (ML) analysis (Felsenstein, 1981) was executed through a heuristic search, facilitated by MEGA 10.2 (Takeuchi et al., 2018).
3 Results
3.1 Endophytic fungal isolates
From 44 healthy Eucalyptus leaf, fruit and branch samples, a total of 754 endophytic fungal isolates were obtained, including 389 isolates from leaves, 197 from fruits, and 168 from branches (Figure 1). One hundred seventy isolates were subsequently selected as representatives, with 95 isolates from leaves, 47 from branches, and 28 from fruits, based on their morphological characteristics and growth rates for biocontrol assays.
Figure 1

The relative abundance (%) of Eucalyptus fungal endophytes isolated from different tissues and regions.
Overall, 27 fungal genera were identified through their morphological features, including Alternaria, Aspergillus, Bipolaris, Botrytis, Chaetomium, Cladosporium, Coniosporium, Cytospora, Didymella, Didymosphaeria, Fusarium, Gymnoascus, Hyalocylindrophora, Iodophanus, Microsphaeropsis, Neofusicoccum, Neoschizothecium, Niesslia, Paecilomyces, Penicillium, Pestalotiopsis, Peziza, Phaeophleospora, Pseudosydowia, Rhizopus, Trichoderma and Ulocladium. Based on the results, the most frequently isolated endophytes from fruits, leaves, and branches belonged to the Neofusicoccum, Cladosporium, and Chaetomium genera, respectively.
3.2 Screening of endophytic fungi for antifungal activity
Based on the results of the primary triple spot culture test, 50 isolates exhibited antagonistic effects against all four pathogens (Supplementary Table S2). In the following stage, five isolates with the highest inhibitory effect were selected for the dual culture test.
3.2.1 Dual culture test
Five selected isolates exhibited potential activity against B. cinerea B2, F. oxysporum f. sp. lycopersici, M. phaseolina M14 and R. solani 124. Selected endophytic isolates, namely Trichoderma sp. 8S1, Trichoderma sp. KL1, Chaetomium sp. DL4, Phaeophleospora sp. XL4, and Pseudosydowia sp. VL3 showed different inhibitory rates (%) against each pathogen, and both Trichoderma sp. isolates displayed the highest inhibition against the mycelia growth of the pathogens (Figures 2, 3).
Figure 2

Growth inhibition percent of fungal pathogens [(A) B2: B. cinerea B2, (B) FOL: F. oxysporum f. sp. lycopersici, (C) M14: M. phaseolina M14, (D) R.S: R. solani 124] by endophytic fungi (KL1: Trichoderma sp. KL1, 8S1: Trichoderma sp. 8S1, DL4: Chaetomium sp. DL4, XL4: Phaeophleospora sp. XL4, and VL3: Pseudosydowia sp. VL3) in dual culture test. Data are presented as means ± standard error (SE) based on three replicates. According to Duncan’s multiple range test, values with different letters indicate statistically significant differences (p ≤ 0.05).
Figure 3

Inhibition of pathogens mycelia growth after 7 days in dual culture test. KL1: Trichoderma sp. KL1, 8S1: Trichoderma sp. 8S1, DL4: Chaetomium sp. DL4, XL4: Phaeophleospora sp. XL4, and VL3: Pseudosydowia sp. VL3.
3.2.2 Volatile organic compound-mediated interactions
According to the results, the VOCs produced by all antagonists inhibited the growth of B. cinerea mycelia with the isolate Trichoderma sp. KL1 by more than 80% exhibits the highest inhibition. Except Chaetomium sp. DL4, all other isolates showed inhibitory effects on the mycelial growth of Fusarium oxysporum f. sp. lycopersici. Additionally, both Trichoderma sp. isolates exhibited the strongest inhibition, exceeding 70%. In contrast, Pseudosydowia sp. VL3 displayed the lowest inhibitory activity, with approximately 54% inhibition against Fusarium oxysporum f. sp. lycopersici. Among the five investigated isolates, only Trichoderma sp. KL1 produced VOCs that effectively inhibited the mycelial growth of M. phaseolina M14 (60%) and R. solani 124 (55%). Other isolates showed no inhibition against these two pathogens. In particular, Trichoderma sp. KL1 reduced M. phaseolina microsclerotia formation (Figures 4, 5).
Figure 4

Growth inhibition percent of fungal pathogens [(A) B2: B. cinerea B2, (B) FOL: F. oxysporum f. sp. lycopersici, (C) M14: M. phaseolina M14, (D) R.S: R. solani 124] by endophytic fungi (KL1: Trichoderma sp. KL1, 8S1: Trichoderma sp. 8S1, DL4: Chaetomium sp. DL4, XL4: Phaeophleospora sp. XL4, and VL3: Pseudosydowia sp. VL3) in volatile organic compound test. Data are presented as means ± standard error (SE) based on three replicates. According to Duncan’s multiple range test, values with different letters indicate statistically significant differences (p ≤ 0.05).
Figure 5
Inhibition of mycelia growth of fungal pathogens after 7 days in volatile organic compounds tests. KL1: Trichoderma sp. KL1, 8S1: Trichoderma sp. 8S1, DL4: Chaetomium sp. DL4, XL4: Phaeophleospora sp. XL4, and VL3: Pseudosydowia sp. VL3.
3.2.3 Enzyme activity and phosphate solubilization
Based on the results of cellulase secretion, all isolates except Pseudosydowia sp. VL3 showed cellulase activity. Similarly, the capacity for chitinase secretion was observed among all 5 isolates, as evidenced by the presence of a transparent halo surrounding the colonies (Table 1).
Table 1
| Isolates | Cellulase | Chitinase | Phosphate solubilization |
|---|---|---|---|
| Trichoderma sp. KL1 | 3.19 ± 0.84* | 1.89 ± 0.80 | 1.29 ± 0.11 |
| Trichoderma sp. 8S1 | 3.48 ± 0.95 | 2.79 ± 0.35 | 1.27 ± 0.05 |
| Chaetomium sp. DL4 | 1.33 ± 0.08 | 1.84 ± 0.56 | 1.31 ± 0.11 |
| Phaeophleospora sp. XL4 | 1.41 ± 0.49 | 2.04 ± 0.49 | 0.00 ± 0.00 |
| Pseudosydowia sp. VL3 | 0.00 ± 0.00 | 1.71 ± 0.53 | 0.00 ± 0.00 |
Enzyme activity and phosphate solubilization of selected endophytic fungal isolates.
*The mean of halo zone diameter/ colony diameter ± standard deviation.
The results also revealed that only isolates Trichoderma sp. 8S1, Trichoderma sp. KL1, and Chaetomium sp. DL4 demonstrated the capability to decompose phosphate and concurrently produce a transparent halo (Table 1).
3.3 Biocontrol assays under greenhouse conditions
The results of greenhouse tests showed that each endophytic isolate possesses a distinct and remarkable capability in controlling each pathogen. Isolate Trichoderma sp. KL1 consistently demonstrated the strongest inhibitory effects against B. cinerea, F. oxysporum f. sp. lycopersici, and M. phaseolina. Conversely, Trichoderma sp. 8S1 exhibited the highest inhibition against R. solani. Additionally, Phaeophleospora sp. XL4 displayed the lowest inhibitory activity against B. cinerea and F. oxysporum f. sp. lycopersici, while Trichoderma sp. 8S1 and Pseudosydowia sp. VL3 showed the lowest inhibition against M. phaseolina and R. solani, respectively (Figures 6, 7).
Figure 6

Antagonistic effect of endophytic fungi (KL1: Trichoderma sp. KL1, 8S1: Trichoderma sp. 8S1, DL4: Chaetomium sp. DL4, XL4: Phaeophleospora sp. XL4, and VL3: Pseudosydowia sp. VL3.) against pathogenic isolates [(A) B2: B. cinerea B2, (B) FOL: F. oxysporum f. sp. lycopersici, (C) M14: M. phaseolina M14, (D) R.S: R. solani 124] in biocontrol tests on tomato plants under greenhouse conditions. Data are presented as means ± standard error (SE) based on six replicates. According to Duncan’s multiple range test, values with different letters indicate statistically significant differences (p ≤ 0.05).
Figure 7

Effect of endophyte isolates (KL1: Trichoderma sp. KL1, 8S1: Trichoderma sp. 8S1, DL4: Chaetomium sp. DL4, XL4: Phaeophleospora sp. XL4, and VL3: Pseudosydowia sp. VL3) on development of symptoms caused by pathogens (B. cinerea B2, F. oxysporum f. sp. lycopersici, M. phaseolina M14, and R. solani 124) on tomato plants under greenhouse conditions.
3.4 The endophytic fungi effect on the growth indices of tomato plants
Plants inoculated exclusively with endophytic fungi did not exhibit any substantial variation in terms of fresh weight, dry weight, and the height of aerial part in comparison to their healthy treatments. On the other hand, a notable disparity was observed among the growth indices of plants treated with endophytic fungi and pathogens, in comparison to those plants that had been treated only with pathogens. It is remarkable that the decline in these indices was less pronounced relative to the healthy controls (Tables 2–5).
Table 2
| Treatments | Heights (cm) | Fresh weight (g) | Dry weight (g) |
|---|---|---|---|
| B2 + KL1 | 33.54 ± 2.81 a | 9.99 ± 0.87 abcd | 1.54 ± 0.31 ab |
| B2 + 8S1 | 33.10 ± 3.38 a | 9.44 ± 0.99 abcde | 1.11 ± 0.21 bc |
| B2 + DL4 | 28.58 ± 3.56 a | 8.01 ± 1.28 cdef | 0.75 ± 0.17 bc |
| B2 + XL4 | 27.63 ± 3.75 a | 7.65 ± 1.47 fe | 0.70 ± 0.11 bc |
| B2 + VL3 | 29.35 ± 3.16 a | 10.31 ± 1.83 abc | 0.90 ± 0.16 bc |
| KL1 | 34.81 ± 1.93 a | 10.18 ± 1.13 abcd | 1.75 ± 0.44 a |
| 8S1 | 33.44 ± 2.98 a | 10.05 ± 1.04 abcd | 1.76 ± 0.22 a |
| DL4 | 31.53 ± 3.42 a | 9.36 ± 0.91 abcde | 1.15 ± 0.23 bc |
| XL4 | 29.78 ± 3.79 a | 8.76 ± 1.27 bcde | 0.80 ± 0.13 bc |
| VL3 | 30.43 ± 3.98 a | 10.42 ± 1.58 ab | 0.93 ± 0.18 abc |
| B2 | 14.80 ± 3.37 b | 6.26 ± 1.28 f | 0.50 ± 0.15 d |
| Control | 23.00 ± 2.99 a | 8.46 ± 1.44 bcdf | 0.77 ± 0.17 bc |
The average fresh weight (g), dry weight (g), and height (cm) of tomato plants inoculated with B. cinerea B2 and treated with endophytic fungi in the pot experiment.
Data are presented as means ± standard error (SE) based on six replicates (three pots with two plants each). Means with different letters in each column are significantly different according to Duncan’s multiple range test (p ≤ 0.05). B2: B. cinerea B2, KL1: Trichoderma sp. KL1, 8S1: Trichoderma sp. 8S1, DL4: Chaetomium sp. DL4, XL4: Phaeophleospora sp. XL4, and VL3: Pseudosydowia sp. VL3.
Table 3
| Treatments | Aerial fresh weight (g) | Root fresh weight (g) | Aerial dry weight (g) | Root fresh weight (g) | Height (cm) |
|---|---|---|---|---|---|
| FOL + KL1 | 7.63 ± 1.08 a | 1.30 ± 023 bcd | 1.02 ± 0.48 ab | 0.42 ± 0.31 ab | 33.67 ± 1.37 a |
| FOL + 8S1 | 8.21 ± 1.06 a | 1.17 ± 0.31 cd | 1.12 ± 0.15 a | 0.65 ± 0.18 ab | 34.50 ± 2.26 a |
| FOL + DL4 | 7.85 ± 0.96 a | 1.20 ± 0.42 bcd | 1.11 ± 0.26 a | 0.50 ± 0.15 ab | 34.33 ± 1.97 a |
| FOL + XL4 | 7.74 ± 0.98 a | 1.19 ± 0.37 bcd | 1.29 ± 0.34 a | 0.60 ± 0.24 ab | 34.17 ± 2.14 a |
| FOL + VL3 | 8.68 ± 1.44 a | 1.21 ± 0.24 bcd | 1.26 ± 0.20 a | 0.50 ± 0.18 ab | 34.83 ± 2.93 a |
| KL1 | 8.00 ± 0.93 a | 1.28 ± 0.31 bcd | 1.25 ± 0.40 a | 0.57 ± 0.20 ab | 34.50 ± 2.23 a |
| 8S1 | 8.80 ± 1.06 a | 1.19 ± 0.27 bcd | 1.24 ± 0.47 a | 0.68 ± 0.23 a | 34.67 ± 2.42 a |
| DL4 | 8.16 ± 0.78 a | 1.22 ± 0.34 bcd | 1.40 ± 0.34 a | 0.65 ± 0.16 ab | 34.50 ± 2.26 a |
| XL4 | 8.71 ± 0.88 a | 1.20 ± 0.34 bcd | 1.27 ± 0.50 a | 0.62 ± 0.26 ab | 34.67 ± 1.37 a |
| VL3 | 8.62 ± 1.15 a | 1.23 ± 0.36 bcd | 1.20 ± 0.30 a | 0.58 ± 0.25 ab | 33.67 ± 1.86 a |
| FOL | 6.02 ± 1.73 b | 0.77 ± 0.28 d | 0.59 ± 0.15 b | 0.30 ± 0.11 ab | 33.00 ± 1.79 a |
| Control | 8.32 ± 0.81 a | 1.32 ± 0.32 bcd | 1.26 ± 0.25 a | 0.51 ± 0.21 ab | 33.83 ± 2.14 a |
The average fresh weight (g), dry weight (g), and height (cm) of tomato plants inoculated with F. oxysporum f. sp. lycopersici race 3, and treated with endophytic fungi in the pot experiment.
Data are presented as means ± standard error (SE) based on six replicates (three pots with two plants each). Means with different letters in each column are significantly different according to Duncan’s multiple range test (p ≤ 0.05). FOL: F. oxysporum f. sp. lycopersici, KL1: Trichoderma sp. KL1, 8S1: Trichoderma sp. 8S1, DL4: Chaetomium sp. DL4, XL4: Phaeophleospora sp. XL4, and VL3: Pseudosydowia sp. VL3.
Table 4
| Treatments | Aerial fresh weight (g) | Root fresh weight (g) | Aerial dry weight (g) | Root fresh weight (g) | Height (cm) |
|---|---|---|---|---|---|
| M14 + KL1 | 8.22 ± 0.92 a | 1.45 ± 0.32 a | 1.16 ± 0.33 a | 0.53 ± 0.20 a | 33.17 ± 1.72 a |
| M14 + 8S1 | 8.16 ± 0.95 a | 1.50 ± 0.19 a | 1.25 ± 0.50 a | 0.59 ± 0.11 a | 34.00 ± 1.67 a |
| M14 + DL4 | 8.29 ± 0.48 a | 1.39 ± 0.33 a | 1.45 ± 0.37 a | 0.56 ± 0.10 a | 34.00 ± 2.37 a |
| M14 + XL4 | 8.38 ± 0.84 a | 1.32 ± 0.17 a | 1.20 ± 0.30 a | 0.58 ± 0.13 a | 34.33 ± 1.63 a |
| M14 + VL3 | 8.50 ± 0.83 a | 1.35 ± 0.27 a | 1.20 ± 0.65 a | 0.57 ± 0.19 a | 33.50 ± 1.87 a |
| KL1 | 8.35 ± 1.01 a | 1.54 ± 0.21 a | 1.66 ± 0.22 a | 0.54 ± 0.19 a | 34.17 ± 2.23 a |
| 8S1 | 8.24 ± 0.96 a | 1.55 ± 0.25 a | 1.33 ± 0.40 a | 0.64 ± 0.13 a | 34.17 ± 2.56 a |
| DL4 | 8.29 ± 1.01 a | 1.39 ± 0.24 a | 1.68 ± 0.76 a | 0.61 ± 0.07 a | 34.33 ± 2.42 a |
| XL4 | 8.35 ± 1.02 a | 1.37 ± 0.43 a | 1.50 ± 0.27 a | 0.58 ± 0.10 a | 34.50 ± 1.87 a |
| VL3 | 8.94 ± 1.48 a | 1.42 ± 0.28 a | 1.49 ± 0.88 a | 0.58 ± 0.15 a | 34.67 ± 1.97 a |
| M14 | 6.23 ± 0.83 b | 0.78 ± 0.20 b | 0.80 ± 0.15 b | 0.44 ± 0.10 a | 32.83 ± 1.17 a |
| Control | 8.58 ± 0.78 a | 1.37 ± 0.24 a | 1.37 ± 0.24 a | 0.56 ± 0.28 a | 34.17 ± 1.72 a |
The average fresh weight (g), dry weight (g), and height (cm) of tomato plants inoculated with M. phaseolina M14, and treated with endophytic fungi in the pot experiment.
Data are presented as means ± standard error (SE) based on six replicates (three pots with two plants each). Means with different letters in each column are significantly different according to Duncan’s multiple range test (p ≤ 0.05). M14: M. phaseolina M14, KL1: Trichoderma sp. KL1, 8S1: Trichoderma sp. 8S1, DL4: Chaetomium sp. DL4, XL4: Phaeophleospora sp. XL4, and VL3: Pseudosydowia sp. VL3.
Table 5
| Treatments | Aerial fresh weight (g) | Aerial fresh weight (g) | Root fresh weight (g) | Aerial dry weight (g) | Root fresh weight (g) | Height (cm) |
|---|---|---|---|---|---|---|
| R.S + KL1 | 2.53 ± 0.56 a | 2.53 ± 0.56 a | 0.66 ± 0.09 a | 0.87 ± 0.16 a | 0.330 ± 0.09 ab | 23.17 ± 1.94 a |
| R.S + 8S1 | 2.42 ± 0.61 a | 2.42 ± 0.61 a | 0.64 ± 0.13 a | 0.82 ± 0.19 a | 0.35 ± 0.09 ab | 22.83 ± 1.47 a |
| R.S + DL4 | 2.36 ± 0.54 a | 2.36 ± 0.54 a | 0.60 ± 0.05 a | 0.81 ± 0.17 a | 0.31 ± 0.05 ab | 21.83 ± 1.47 a |
| R.S + XL4 | 2.28 ± 0.40 a | 2.28 ± 0.40 a | 0.64 ± 0.08 a | 0.77 ± 0.13 a | 0.30 ± 0.05 ab | 22.33 ± 1.63 a |
| R.S + VL3 | 2.12 ± 0.33 a | 2.12 ± 0.33 a | 0.60 ± 0.06 a | 0.73 ± 0.10 a | 0.29 ± 0.04 ab | 22.50 ± 1.52 a |
| KL1 | 2.57 ± 0.45 a | 2.57 ± 0.45 a | 0.70 ± 0.12 a | 0.89 ± 0.13 a | 0.37 ± 0.08 a | 24.00 ± 2.53 a |
| 8S1 | 2.60 ± 0.49 a | 2.60 ± 0.49 a | 0.70 ± 0.19 a | 0.88 ± 0.16 a | 0.37 ± 0.11 a | 23.67 ± 1.37 a |
| DL4 | 2.43 ± 0.58 a | 2.43 ± 0.58 a | 0.60 ± 0.08 a | 0.84 ± 0.18 a | 0.33 ± 0.09 ab | 22.67 ± 2.34 a |
| XL4 | 2.44 ± 0.51 a | 2.44 ± 0.51 a | 0.70 ± 0.10 a | 0.82 ± 0.16 a | 0.32 ± 0.07 ab | 23.00 ± 2.00 a |
| VL3 | 2.42 ± 0.41 a | 2.42 ± 0.41 a | 0.64 ± 0.06 a | 0.82 ± 0.13 a | 0.32 ± 0.05 ab | 22.33 ± 1.63 a |
| R.S | 1.99 ± 0.18 a | 1.99 ± 0.18 a | 0.51 ± 0.08 a | 0.68 ± 0.05 a | 0.23 ± 0.04 b | 21.00 ± 1.41 a |
| Control | 2.11 ± 0.23 a | 2.11 ± 0.23 a | 0.57 ± 0.08 a | 0.72 ± 0.08 a | 0.29 ± 0.04 ab | 22.33 ± 1.51 a |
The average fresh weight (g), dry weight (g), and height (cm) of tomato plants inoculated with R. solani 124, and treated with endophytic fungi in the pot experiment.
Data are presented as means ± standard error (SE) based on six replicates (three pots with two plants each). Means with different letters in each column are significantly different according to Duncan’s multiple range test (p ≤ 0.05). R.S: R. solani 124, KL1: Trichoderma sp. KL1, 8S1: Trichoderma sp. 8S1, DL4: Chaetomium sp. DL4, XL4: Phaeophleospora sp. XL4, and VL3: Pseudosydowia sp. VL3.
3.5 Endophytic colonization of tomato plant by fungal isolates
Endophytic colonization was assessed by recovering the inoculated fungal isolates from the roots, stems, and leaves of tomato plants. After a two-week inoculation period, all 5 fungal isolates were successfully recovered from various tissues of host plants, indicating their systemic colonization ability in tomato plant.
3.6 Molecular identification of antagonistic endophytes
Five endophytic isolates including Trichoderma sp. KL1, Trichoderma sp. 8S1, Chaetomium sp. DL4, Phaeophleospora sp. XL4, and Pseudosydowia sp. VL3 with antagonistic effect on pathogens, were identified based on the morphological features and molecular data.
The ITS region was sequenced for isolates Chaetomium sp. DL4, Phaeophleospora sp. XL4, and Pseudosydowia sp. VL3, while the ef-1α partial gene was sequenced for Trichoderma isolates. Analysis revealed that isolates DL4, VL3, and XL4 clustered separately, corresponding to Chaetomium globosum Kunze, Pseudosydowia eucalypti (Verwoerd and du Plessis) Thambug. and K.D. Hyde, and Phaeophleospora eucalypticola Crous and M.J. Wingf. species, respectively (Figure 8). Furthermore, isolates 8S1 and KL1 were grouped with Trichoderma longibrachiatum Rifai and Trichoderma bissettii Sand.-Den. and Guarro (Figure 9). Since these species are inseparable via the ef-1α region, but differ morphologically, isolates KL1 and 8S1 were confirmed as T. longibrachiatum through a combination of morphological analysis and molecular data comparison.
Figure 8

Maximum Likelihood (ML) tree based on aligned sequences of ITS gene of 35 isolates generated in MEGA 10 under K2 + G + I model. The tree was rooted to Gloeophyllum sepiarium. Bootstrap values (1,000 replicates) indicated at the nodes. The scale bar indicates nucleotide substitution in ML analysis, values ≥50% are shown above/below the branches. The surveyed isolates in the current study are highlighted in red.
Figure 9

Maximum Likelihood (ML) tree based on aligned sequences of tef-1α gene of 31 isolates generated in MEGA 10 under HKY + G model. The tree was rooted to Aciculosporium siamense. Bootstrap values (1,000 replicates) indicated at the nodes. The scale bar indicates nucleotide substitution in ML analysis, values ≥50% are shown above/below the branches. The surveyed isolates in the current study are highlighted in red.
4 Discussion
Endophytic fungi can enhance plant defense, degrade fungal structures, or provide essential nutrients, thereby significantly strengthening their antagonistic capabilities. Chitinases, enzymes that break down insoluble polymers, play a vital role in various fungal processes, including hyphal tube growth, sporulation, spore germination, cell division, and mycoparasitism against other microbes (De Marco et al., 2000; Karlsson and Stenlid, 2008). Plants utilize chitinases as a defensive mechanism against pathogens (Regalado et al., 2000; Hietala et al., 2004; Onaga and Taira, 2008) Furthermore, cellulases produced by endophytic fungi can contribute to plant defense by stimulating their immune responses (Amirita et al., 2012).
The aim of this study was isolation, identification, and selection of endophytic isolates with biocontrol potential against some important pathogens. Therefore, various tests were conducted in vitro and in greenhouse conditions. Among 754 fungal isolates obtained from 44 plant samples, 27 fungal genera were identified. Overall, the most prevalent endophytic isolates were found within the Neofusicoccum, Cladosporium, Didymosphaeria, and Chaetomium genera. In the study conducted by Fisher et al. (1993) on endophytic fungi found in Eucalyptus leaves and branches, the most common species identified were Botryosphaeria dothidea (Moug.) Ces. and De Not., and Cytospora eucalypticola Van der Westh. Also, Lupo et al. (2001), focusing on isolating species from flowers, capsules, and seeds of E. globulus Labill., identified Cytospora chrysosperma (Pers.) Fr., Fusicoccum eucalypti Sousa da Câmara, Alternaria alternata (Fr.) Keissl., Fairmaniella leprosa (Fairm.) Petr. and Syd., Aureobasidium pullulans (de Bary and Löwenthal) G. Arnaud, and Cladosporium cladosporioides (Fresen.) G.A. de Vries as endophytes. Further research by Lacerda et al. (2018) into the fungal endophytes’ communities of E. microcorys led to the discovery of Castanediella eucalypticola Crous and M.J. Wingf., and Neophaeomoniella eucalypti Roon.-Lath. and Crous in Brazil. An investigation into the endophytes of E. globulus twigs yielded 127 fungal isolates, including Pringsheimia smilacis E. Müll., Lophiostoma corticola (Fuckel) E.C.Y. Liew, Aptroot and K.D. Hyde, Hormonema sp., Neofusicoccum luteum (Pennycook and Samuels) Crous, Slippers and A.J.L. Phillips, Phaeomoniella effuse Damm and Crous, and Ulocladium sp., all identified as laccase positive strains (Fillat et al., 2016).
When different microbial species coexist within the same plant, endophytes and the host plant secrete metabolites that inhibit the growth of harmful microorganisms (Latz et al., 2018). Some endophytic fungi can suppress plant pathogens through various mechanisms, including induced resistance, antibiosis, hyperparasitism, and competition (Latz et al., 2018; Wei et al., 2019). These mechanisms may vary depending on the specific pathogen and can be employed individually or in combination (Wei et al., 2019; Aleahmad and Ebrahimi, 2023). Hyperparasitism is a mechanism employed by endophytes to protect their host plants against pathogens. In this process, endophytes directly attack pathogens by twisting and penetrating their hyphae and destroying their cell walls through the production of lyases (Fadiji and Babalola, 2020). Endophytes have been found to contain antibiotics and secondary metabolites with antimicrobial properties, including flavonoids, peptides, quinones, alkaloids, phenols, phenolic acids, steroids, terpenoids, VOCs, benzopyranones, chinones, saponins, tannins, tetralones, and xanthones, polyketides and different enzymes (Lugtenberg et al., 2016; Strobel, 2018; Elawady et al., 2023). VOCs are organic chemicals that readily evaporate at room temperature and pressure. Characterized by low molecular weights and high vapor pressures, they are easily transported in air and soil after release (Poveda, 2021). Over 250 different VOCs, primarily acids, alcohols, aldehydes, aromatics, esters, heterocycles, ketones, terpenes, and thiols, have been identified in fungi. These VOCs can be broadly classified into five categories: terpenoids, fatty acid derivatives, benzene compounds, acetone, and amino acid derivatives (Ling et al., 2024). In the current research, antifungal properties of purified endophytic fungi were evaluated against the pathogenic fungi B. cinerea, F. oxysporum f. sp. lycopersici, M. phaseolina, and R. solani through dual culture, VOC production, and enzyme production tests. Findings revealed that all tested endophytes exhibited over 85% inhibitory activity against B. cinerea in both dual culture and VOC tests. Furthermore, they significantly hindered the growth of M. phaseolina mycelia by up to 63%, and reduced microsclerotia formation. Against F. oxysporum f. sp. lycopersici, all isolates demonstrated over 68% inhibitory activity in dual culture test, although Ch. Globosum DL4 showed variable results in VOC production. Moreover, most isolates inhibited R. solani growth by approximately 70% in dual culture test, with T. longibrachiatum KL1 also displaying inhibitory activity in VOC production. Previous studies have demonstrated the antifungal potential of endophytes, particularly T. longibrachiatum and T. harzianum Rifai. Rajani et al. (2021) reported over 88% inhibition of mycelial growth for pathogens including S. sclerotiorum (Lib.) de Bary, S. rolfsii Sacc. 1911, M. phaseolina, and F. oxysporum in dual culture test. Additionally, VOC production test indicated inhibitory activity exceeding 50% against S. sclerotiorum, Sclerotium rolfsii, and F. oxysporum, but not against M. phaseolina.
Another study highlighted the antifungal potential of endophyte strains isolated from rice leaves, including Paecilomyces tenuis Y.F. Han and Z.Q. Liang, Talaromyces pinophilus (Hedgc.) Samson, N. Yilmaz, Frisvad and Seifert, Nigrospora sphaerica (Sacc.) E.W. Mason, Nigrospora oryzae (Berk. and Broome) Petch, Aspergillus terreus Thom, and T. longibrachiatum. These strains demonstrated inhibitory activity against pathogens like Magnaporthe grisea (T.T. Hebert) M.E. Barr, M. phaseolina, Pythium sp., F. oxysporum, R. solani, and Colletotrichum falcatum Went in dual culture test. Notably, T. longibrachiatum also showed inhibitory activity in VOC production test (Roy and Banerjee, 2019).
Endophytes with the capacity to secrete extracellular chitinase contribute to the degradation of chitin, a β-(1,4)-linked polymer of N-acetyl-D-glucosamine, and the cell wall structure of most phytopathogenic fungi, alongside the synthesis of other multifaceted bioactive compounds (Hartl et al., 2012; Ebrahimi et al., 2022). Endophytes, including non-pathogenic microorganisms, can induce systemic resistance and activate specific genes involved in pathogenesis (Fadiji and Babalola, 2020). Some endophytes can degrade plant lignin and cellulose and secrete chitinase, which induces the host plant’s immune system and decomposes the cell walls of phytopathogenic fungi, respectively (Ebrahimi et al., 2022). The current study revealed that all isolates, except Ps. eucalypti VL3, could produce cellulase, and all isolates produced chitinase, with Trichoderma sp. 8S1 exhibiting the highest levels of both. Pedrero-Méndez et al. (2021) reported significant cellulolytic and chitinolytic activity in various Trichoderma sp. endophytes isolated from wheat. Additionally, a Trichoderma sp. from almonds was found to secrete chitinase, which degraded the cell wall of B. cinerea and mitigated disease symptoms (Aoki et al., 2020). Endophytic Trichoderma viride Pers. and Trichoderma koningii Oudem., through chitinase, protease, and glucanase production, degraded M. phaseolina cell wall, significantly inhibiting its growth (Gajera et al., 2023). Research by Ebrahimi et al. (2022) highlighted cellulolytic activity in apple-isolated endophytes like Aureobasidium microstictum (Bubák) W.B. Cooke, Fusarium lateritium Nees 6, and Coniochaeta endophytica A.H. Harrington and A.E. Arnold, with Ch. Globosum and F. lateritium displaying chitinolytic activity. Further studies on endophytes from medicinal plants like Terminalia catappa and T. mantaly revealed high cellulase production by Penicillium chermesinum Biourge (Toghueo et al., 2017).
Endophytic microorganisms, similar to rhizosphere microbes, play a vital role in plant growth and development (Santoyo et al., 2016). These fungi can enhance the fitness and growth of host plants by facilitating the production of phytohormones, siderophores, indolic compounds, phosphate solubilization and nutrients production such as polysaccharides, lipids, minerals and vitamins (Sharma and Goyal, 2017; Ling et al., 2024). The solubilization of inorganic insoluble phosphate (Plants can then absorb this soluble phosphate) by various microorganisms depends on their ability to produce organic acids in their specific environment (Sharma and Goyal, 2017). This study showed the phosphate solubilization capabilities of the endophytic fungi T. longibrachiatum KL1, T. longibrachiatum 8S1, and Ch. Globosum DL4. Previous studies have also identified phosphate-solubilizing endophytes, such as T. longibrachiatum isolated from peanuts (Al-Askar et al., 2022), C. endophytica and F. lateritium (Ebrahimi et al., 2022), and various species associated with cucumbers, including Aspergillus niger Tiegh., Aspergillus japonicus Saito, T. viride, and Ch. Globosum (Yadav et al., 2020). These endophytes can contribute to plant growth promotion by solubilizing phosphate.
The fungus Ps. eucalypti, previously known as Sphaerulina eucalypti Verwoerd and du Plessis, was identified in 1931 as the causative agent of leaf spot disease in African Eucalyptus trees (Verwoerd, 1931). Recent studies in California highlighted its frequent association with Eucalyptus decline and dieback, characterized by leaf spots and shoot tip necrosis. The presence of Ps. eucalypti in Eucalyptus cultivation areas suggests its potential endophytic lifestyle within the plant (Garbelotto et al., 2021). Additionally, Ph. eucalypticola, reported in Australia (Crous et al., 2016), was later identified as a pathogen on pine species in South Korea (Choi et al., 2022). This study presents the first documented occurrence of Ps. eucalypti and Ph. eucalypticola isolates in Iran, establishing their global presence as endophytes. Research highlights the variability in pathogenicity among fungal isolates, with some being non-pathogenic and capable of suppressing pathogenic species when applied preemptively to host plants (Alabouvette et al., 2009; Kaur et al., 2011; Iida et al., 2022; Ebrahimi et al., 2023).
Such interactions can either directly or indirectly mitigate disease progression, making non-pathogenic strains valuable biological control agents (Alabouvette et al., 1993; Kaur et al., 2011; Saito et al., 2021; Ebrahimi et al., 2023). These strains can induce systemic resistance within plants, as demonstrated by the use of non-pathogenic F. oxysporum strains to manage Fusarium wilt (Iida et al., 2022) and non-pathogenic F. fujikuroi strains to control B. cinerea and M. phaseolina (Ebrahimi et al., 2023). Furthermore, non-pathogenic Fusarium spp. strains effectively suppressed rice bakanae disease (Saito et al., 2021), underscoring the potential of non-pathogenic fungal strains in crop protection strategies. Greenhouse tests evaluated the efficacy of selected fungal isolates as biological control agents against specific plant diseases. Among the investigated isolates, Ph. eucalypticola XL4 controlled gray mold disease by 63%, while T. longibrachiatum KL1 achieved complete control (100%), and T. longibrachiatum 8S1 reached 98%. However, Ph. eucalypticola XL4 was less effective against Fusarium wilt disease, controlling it by only 37%, compared to other isolates that exceeded 75% control. For charcoal rot disease, T. longibrachiatum 8S1 and Ch. Globosum DL4 surpassed 70% control, while others reached over 80%. In combating Rhizoctonia damping-off disease, T. longibrachiatum isolates consistently demonstrated superior control, exceeding 80%, followed by other isolates with varying degrees of success. Studies by Tadayyon Rad and Ebrahimi (2023), showed that Ch. globosum isolates inhibited M. phaseolina mycelial growth by over 67% in vitro and 90% in greenhouse. Park et al. (2019) highlighted Trichoderma sp. potential in controlling grey mold and charcoal rot diseases through mechanisms like phosphate solubilization, chitinase production, and cellulase activity, significantly reducing disease symptoms in tomato plant. Endophytic Paecilomyces formosus Sakag., May. Inoue and Tada ex Houbraken and Samson, isolated from tomato plants, demonstrated the ability to degrade R. solani cell walls using various enzymes, alongside phosphate and zinc solubilization, leading to a significant reduction in disease symptoms in greenhouse conditions. Further research involving Rhizoctonia and Fomes isolates from wheat and wild barley demonstrated their potential to reduce symptoms caused by F. oxysporum f. sp. lycopersici and inhibit mycelial growth. Among these isolates, Coprinopsis urticicola (Berk. and Broome) Redhead, Vilgalys and Moncalvo was the only one found to be effective in greenhouse.
The evidences indicate that the effectiveness of antagonist factors, including endophytes, depends on the pathogen (even different isolates of the same pathogen) and the host plant (Ebrahimi et al., 2023). The interactions between plants and endophytes are very complex and vary from host to host, and endophyte to endophyte (Gupta et al., 2020; Ebrahimi et al., 2023). Endophytic fungal isolates demonstrated significant inhibitory effects against B. cinerea. Among the isolates tested, T. longibrachiatum KL1 and T. longibrachiatum 8S1 exhibited the highest inhibition rates, reaching 100 and 98%, respectively. In contrast, Ph. eucalypticola XL4 showed the lowest inhibition, with approximately 63%. Similarly, endophytic fungal isolates demonstrated varying levels of inhibition against F. oxysporum f. sp. lycopersici. T. longibrachiatum KL1 exhibited the highest inhibitory effect, reaching approximately 92%, while Ph. eucalypticola XL4 showed the lowest inhibition at around 37%. Additionally, T. longibrachiatum KL1 exhibited the highest inhibition rate of approximately 87%, while T. longibrachiatum 8S1 also showed a considerable inhibitory effect of around 70% against charcoal rot agent. Endophytic fungi, particularly T. longibrachiatum KL1 and 8S1, significantly reduced the incidence of Rhizoctonia disease caused by R. solani. These Trichoderma isolates exhibited the highest inhibition rates, exceeding 80%, while Ps. eucalypti VL3 showed a lower inhibition rate of 64%. These results confirmthat the effectiveness of endophytic antagonism depends on pathogen and host plant. Studies conducted by Ebrahimi et al. (2023) showed that endophyte isolates Ch. globosum 2S1, Ch. globosum 3 L2, F. acuminatum Ellis and Everh., F. fujikuroi, and F. incarnatum (Desm.) Sacc. exhibited different levels of inhibitory effect against the pathogens B. cinerea and M. phaseolina.
5 Conclusion
Endophytic fungi are recognized as a vast source with strong potential in biocontrol biotic stresses in agriculture. This study has identified T. longibrachiatum KL1 and T. longibrachiatum 8S1 as promising endophytic fungal isolates capable of inhibiting gray mold, Fusarium wilt, charcoal disease, and Rhizoctonia damping-off in tomato plants under greenhouse conditions. Results suggest that the reduction of disease caused by the mentioned pathogens is attributed to various mechanisms, including the production of volatile and permeable compounds in the culture medium and the secretion of enzymes such as cellulase and chitinase by endophytic fungi. These isolates demonstrated promising compounds derived from endophytes, which could contribute to developing more sustainable approaches for managing plant diseases. Further research is necessary to elucidate the fundamental mechanisms underlying the interactions between endophytic fungi and their host plants. Additionally, it is crucial to validate these findings under field conditions and across a wider range of host plants to ensure the functionality and effectiveness of these biocontrol agents in diverse agricultural ecosystems.
Statements
Data availability statement
The datasets presented in this study can be found in online repositories. The names of the repository/repositories and accession number(s) can be found in the article/Supplementary material.
Author contributions
PA: Data curation, Formal analysis, Writing – original draft. LE: Conceptualization, Funding acquisition, Methodology, Project administration, Resources, Supervision, Validation, Visualization, Writing – review & editing. NS: Conceptualization, Methodology, Supervision, Validation, Writing – review & editing. HE: Validation, Writing – review & editing.
Funding
The author(s) declare that financial support was received for the research, authorship, and/or publication of this article. This work was supported by the Iran National Science Foundation (INSF) (Grant No. 4025483), and University of Tehran, Iran.
Acknowledgments
We gratefully acknowledge the Iran National Science Foundation (INSF), and University of Tehran, Iran, for financial support.
Conflict of interest
The authors declare that the research was conducted in the absence of any commercial or financial relationships that could be construed as a potential conflict of interest.
The author(s) declared that they were an editorial board member of Frontiers, at the time of submission. This had no impact on the peer review process and the final decision.
Generative AI statement
The author(s) declare that Generative AI was used in the creation of this manuscript. Gemini, developed by Google AI, was used to check the grammar and improve readability.
Publisher’s note
All claims expressed in this article are solely those of the authors and do not necessarily represent those of their affiliated organizations, or those of the publisher, the editors and the reviewers. Any product that may be evaluated in this article, or claim that may be made by its manufacturer, is not guaranteed or endorsed by the publisher.
Supplementary material
The Supplementary material for this article can be found online at: https://www.frontiersin.org/articles/10.3389/fmicb.2025.1523127/full#supplementary-material
References
1
Abbasi S. Safaie N. Sadeghi A. Shamsbakhsh M. (2019). Streptomyces strains induce resistance to Fusarium oxysporum f. sp. lycopersici race 3 in tomato through different molecular mechanisms. Front. Microbiol.10:1505. doi: 10.3389/fmicb.2019.01505
2
Ahmad R. S. Imran M. Ahmad M. H. Khan M. K. Yasmin A. Saima H. et al . (2023). “Eucalyptus essential oils” in Essential Oils (Elsevier: Academic Press), 217–239.
3
Alabouvette C. Lemanceau P. Steinberg C. (1993). Recent advances in the biological control of Fusarium wilts. Pestic. Sci.37, 365–373. doi: 10.1002/ps.2780370409
4
Alabouvette C. Olivain C. Migheli Q. Steinberg C. (2009). Microbiological control of soil-borne phytopathogenic fungi with special emphasis on wilt-inducing Fusarium oxysporum. New Phytol.184, 529–544. doi: 10.1111/j.1469-8137.2009.03014.x
5
Al-Askar A. A. Rashad E. M. Moussa Z. Ghoneem K. M. Mostafa A. A. Al-Otibi F. O. et al . (2022). A novel endophytic Trichoderma longibrachiatum WKA55 with biologically active metabolites for promoting germination and reducing mycotoxinogenic fungi of peanut. Front. Microbiol.13:772417. doi: 10.3389/fmicb.2022.772417
6
Aleahmad P. Ebrahimi L. (2023). The possible applications of endophytic fungi. Res. J. Pharmaco.10, 81–94.
7
Amirita A. Sindhu P. Swetha J. Vasanthi N. S. Kannan K. P. (2012). Enumeration of endophytic fungi from medicinal plants and screening of extracellular enzymes. World J Sci Technol2, 13–19.
8
Aoki Y. Haga S. Suzuki S. (2020). Direct antagonistic activity of chitinase produced by Trichoderma sp. SANA20 as biological control agent for grey mould caused by Botrytis cinerea. Cogent Biol.6:1747903. doi: 10.1080/23312025.2020.1747903
9
Attia M. S. Hashem A. H. Badawy A. A. Abdelaziz A. M. (2022). Biocontrol of early blight disease of eggplant using endophytic aspergillus terreus: improving plant immunological, physiological and antifungal activities. Bot. Stud.63:26. doi: 10.1186/s40529-022-00357-6
10
Bardin M. Ajouz S. Comby M. Lopez-Ferber M. Graillot B. Siegwart M. et al . (2015). Is the efficacy of biological control against plant diseases likely to be more durable than that of chemical pesticides?Front. Plant Sci.6:566. doi: 10.3389/fpls.2015.00566
11
Baron N. C. Rigobelo E. C. (2022). Endophytic fungi: a tool for plant growth promotion and sustainable agriculture. Mycology13, 39–55. doi: 10.1080/21501203.2021.1945699
12
Batish D. R. Singh H. P. Kohli R. K. Kaur S. (2008). Eucalyptus essential oil as a natural pesticide. For. Ecol. Manag.256, 2166–2174. doi: 10.1016/j.foreco.2008.08.008
13
Berger L. R. Reynold D. M. (1958). The chitinase system of a strain of Streptomyces griseus. Biochim. Biophys. Acta29, 522–534. doi: 10.1016/0006-3002(58)90008-8
14
Choi J. W. Gwon J. H. Lee J. C. Park H. Eom A. H. (2022). Characterization of three species of Endophytic Fungi isolated from conifer leaves in Korea. Korean J. Mycol.50, 173–181. doi: 10.4489/KJM.20220018
15
Crous P. W. Wingfield M. J. Richardson D. M. Leroux J. J. Strasberg D. Edwards J. et al . (2016). Fungal planet description sheets: 400–468. Persoonia36, 316–458. doi: 10.3767/003158516X692185
16
Carter-House D. Stajich J. E. Unruh S. Kurbessoian T. (2020). Fungal CTAB DNA Extraction V1.
17
De Marco J. L. Lima L. H. C. de Sousa M. V. Felix C. R. (2000). A Trichoderma harzianum chitinase destroys the cell wall of the phytopathogen Crinipellis perniciosa, the causal agent of witches' broom disease of cocoa. World J. Microbiol. Biotechnol.16, 383–386. doi: 10.1023/A:1008964324425
18
Dennis C. Webster J. (1971). Antagonistic properties of species-groups of Trichoderma. II. Production of volatile antibiotics, Transactions of the British Mycological Society, 75, 41–48.
19
Dorrance A. E. Kleinhenz M. D. McClure S. A. Tuttle N. T. (2003). Temperature, moisture, and seed treatment effects on Rhizoctonia solani root rot of soybean. Plant Dis.87, 533–538. doi: 10.1094/PDIS.2003.87.5.533
20
Ebrahimi L. Fotouhifar K. B. (2016). First report of Cyphellophora fusarioides (Chaetothyriales) on a plant host. Sydowia68, 131–137. doi: 10.12905/0380.sydowia68-2016-0131
21
Ebrahimi L. Hatami Rad S. Etebarian H. R. (2022). Apple endophytic fungi and their antagonism against apple scab disease. Front. Microbiol.13:1024001. doi: 10.3389/fmicb.2022.1024001
22
Ebrahimi L. Tadayon Rad F. Lotfi M. (2023). Antagonism of endophytic fungi depends on pathogen and host plant. BioControl68, 655–668. doi: 10.1007/s10526-023-10224-3
23
Elawady M. E. Hamed A. A. Alsallami W. M. Gabr E. Z. Abdel-Monem M. O. Hassan M. G. (2023). Bioactive metabolite from endophytic aspergillus versicolor SB5 with anti-acetylcholinesterase, anti-inflammatory and antioxidant activities: in vitro and in silico studies. Microorganisms11:1062. doi: 10.3390/microorganisms11041062
24
Ellis M. B. (1971). Dematiaceous Hyphomycetes. Kew, England: Commonwealth Mycological Institute, 608.
25
Ellis M. B. (1976). More dematiaceous Hyphomycetes. Kew, England: Commonweath Mycological Institute, 507.
26
Etebarian H. R. Khairi A. Roustaei A. Khodakaramian G. H. Aminian H. (2007). Evaluation of Pseudomonas isolates for biological control of charcoal stem rot of melon caused by Macrophomina phaseolina. Acta Hortic.761, 157–162. doi: 10.17660/ActaHortic.2007.761.20
27
Etebarian H. R. Sholberg P. L. Eastwell K. C. Sayler R. J. (2005). Biological control of apple blue mold with Pseudomonas fluorescens. Can. J. Microbiol.51, 591–598. doi: 10.1139/w05-039
28
Fadiji A. E. Babalola O. O. (2020). Elucidating mechanisms of endophytes used in plant protection and other bioactivities with multifunctional prospects. Front. Bioeng. Biotechnol.8:467. doi: 10.3389/fbioe.2020.00467
29
Felsenstein J. (1981). Evolutionary trees from DNA sequences: a maximum likelihood approach. J. Mol. Evol.17, 368–376. doi: 10.1007/BF01734359
30
Fillat Ú. Martín-Sampedro R. Macaya-Sanz D. Martín J. A. Ibarra D. Martínez M. J. et al . (2016). Screening of Eucalyptus wood endophytes for laccase activity. Process Biochem.51, 589–598. doi: 10.1016/j.procbio.2016.02.006
31
Fisher P. J. Petrini O. S. B. C. Sutton B. C. (1993). A comparative study of fungal endophytes in leaves, xylem and bark of Eucalyptus in Australia and England. Sydowia45, 338–345.
32
Fontana D. C. de Paula S. Torres A. G. de Souza V. H. M. Pascholati S. F. Schmidt D. et al . (2021). Endophytic fungi: biological control and induced resistance to phytopathogens and abiotic stresses. Pathogens10:570. doi: 10.3390/pathogens10050570
33
Gajera H. P. Hirpara D. G. Savaliya D. D. Parakhia M. V. (2023). Biochemical and molecular depictions to develop ech42 gene-specific SCAR markers for recognition of chitinolytic Trichoderma inhibiting Macrophomina phaseolina (Maubl.) Ashby. Arch. Microbiol.205:242. doi: 10.1007/s00203-023-03582-0
34
Garbelotto M. Beitz P. District E.B. (2021). Investigating the fungi responsible for the recent large-scale dieback of blue gum Eucalyptus (Eucalyptus globolus) in the San Francisco Bay Area. Available at: https://nature.berkeley.edu/matteolab/wpcontent/uploads/2022/02/EucalyptusDiebackReportUCBerkeleyWEBSITE.pdf
35
Gilardi G. Matic S. Guarnaccia V. Garibaldi A. Gullino M. L. (2021). First report of Fusarium clavum causing leaf spot and fruit rot on tomato in Italy. Plant Dis.105:2250. doi: 10.1094/PDIS-05-20-1096-PDN
36
Gupta S. Chaturvedi P. Kulkarni M. G. Van Staden J. (2020). A critical review on exploiting the pharmaceutical potential of plant endophytic fungi. Biotechnol. Adv.39:107462. doi: 10.1016/j.biotechadv.2019.107462
37
Hardoim P. R. Van Overbeek L. S. Berg G. Pirttilä A. M. Compant S. Campisano A. et al . (2015). The hidden world within plants: ecological and evolutionary considerations for defining functioning of microbial endophytes. Microbiol. Mol. Biol. Rev.79, 293–320. doi: 10.1128/MMBR.00050-14
38
Hartl L. Zach S. Seidl-Seiboth V. (2012). Fungal chitinases: diversity, mechanistic properties and biotechnological potential. Appl. Microbiol. Biotechnol.93, 533–543. doi: 10.1007/s00253-011-3723-3
39
Hashem A. H. Attia M. S. Kandil E. K. Fawzi M. M. Abdelrahman A. S. Khader M. S. et al . (2023). Bioactive compounds and biomedical applications of endophytic fungi: a recent review. Microb. Cell Factories22:107. doi: 10.1186/s12934-023-02118-x
40
Herrera-Téllez V. I. Cruz-Olmedo A. K. Plasencia J. Gavilanes-Ruíz M. Arce-Cervantes O. Hernández-León S. et al . (2019). The protective effect of Trichoderma asperellum on tomato plants against Fusarium oxysporum and Botrytis cinerea diseases involves inhibition of reactive oxygen species production. Int. J. Mol. Sci.20:2007. doi: 10.3390/ijms20082007
41
Hietala A. M. Kvaalen H. Schmidt A. Jøhnk N. Solheim H. Fossdal C. G. (2004). Temporal and spatial profiles of chitinase expression by Norway spruce in response to bark colonization by Heterobasidion annosum. Appl. Environ. Microbiol.70, 3948–3953. doi: 10.1128/AEM.70.7.3948-3953.2004
42
Hsu S. C. Lockwood J. (1975). Powdered chitin agar as a selective medium for enumeration of actinomycetes in water and soil. Appl. Microbiol.29, 422–426. doi: 10.1128/am.29.3.422-426.1975
43
Iida Y. Ogata A. Kanda H. Nishi O. Sushida H. Higashi Y. et al . (2022). Biocontrol activity of nonpathogenic strains of Fusarium oxysporum: colonization on the root surface to overcome nutritional competition. Front. Microbiol.13:826677. doi: 10.3389/fmicb.2022.826677
44
Jalali H. Ebrahimi L. Etebarian H. R. (2021). Biocontrol of tomato grey mold disease by Trichoderma harzianum and Bacillus subtilis. J. Crop Protect.10, 647–657.
45
Jia Q. Qu J. Mu H. Sun H. Wu C. (2020). Foliar endophytic fungi: diversity in species and functions in forest ecosystems. Symbiosis80, 103–132. doi: 10.1007/s13199-019-00663-x
46
Jimenez-Diaz R. M. Blanco-López M. A. Sackston W. E. (1983). Incidence and distribution of charcoal rot of sunflower caused by Macrophomina phaseolina in Spain. Plant Dis.67:1033.
47
Karlsson M. Stenlid J. (2008). Comparative evolutionary histories of the fungal chitinase gene family reveal non-random size expansions and contractions due to adaptive natural selection. Evol. Bioinforma.4:EBO-S604. doi: 10.4137/EBO.S604
48
Kaur R. Kaur J. Singh R. S. (2011). Nonpathogenic Fusarium as a biological control agent. Plant Pathol. J.9, 79–91. doi: 10.3923/ppj.2010.79.91
49
Klich M. A. (2002). Identification of common aspergillus species. The Netherlands: Central voor Schimmeltures, Uterch, 116.
50
Klich M. A. Pitt J. I. (1988). A laboratory guide to the common aspergillus species and their teleomorphs. Australia: Commonwealth Scientific and Industrial Research Organization, Division of Food Processing, 120.
51
Labate C. A. de Assis T. F. Oda S. de Mello E. J. González E. R. Zauza E. A. V. et al . (2009). “Eucalyptus” in Compendium of transgenic crop plants: Transgenic forest trees species. eds. KoleC. H.HallT. C. (Oxford: Blackwell Publishing), 35–108.
52
Lacerda L. T. Gusmão L. F. Rodrigues A. (2018). Diversity of endophytic fungi in Eucalyptus microcorys assessed by complementary isolation methods. Mycol. Prog.17, 719–727. doi: 10.1007/s11557-018-1385-6
53
Latz M. A. Jensen B. Collinge D. B. Jørgensen H. J. (2018). Endophytic fungi as biocontrol agents: elucidating mechanisms in disease suppression. Plant Ecol. Diver.11, 555–567. doi: 10.1080/17550874.2018.1534146
54
Lillbro M. (2005). Biocontrol of Penicillium roqueforti on grain-acomparison of mode of action of several yeast species master thesis of the agriculture program, animal science, performed at the Department of Microbiology. Uppsala: Swedish University of Agricultural Sciences.
55
Ling L. Feng L. Li Y. Yue R. Wang Y. Zhou Y. (2024). Endophytic fungi volatile organic compounds as crucial biocontrol agents used for controlling fruit and vegetable postharvest diseases. J. Fungi10:332. doi: 10.3390/jof10050332
56
Lugtenberg B. J. Caradus J. R. Johnson L. J. (2016). Fungal endophytes for sustainable crop production. FEMS Microbiol. Ecol.92:194. doi: 10.1093/femsec/fiw194
57
Lupo S. Tiscornia S. Bettucci L. (2001). Endophytic fungi from flowers, capsules and seeds of Eucalyptus globulus. Rev. Iberoam. Micol.18, 38–41
58
Majidi S. Roayaei M. Ghezelbash G. (2011). Carboxymethyl-cellulase and filter-paperase activity of new strains isolated from Persian gulf. Microbiol. J.1, 8–16. doi: 10.3923/mj.2011.8.16
59
Manganyi M. C. Ateba C. N. (2020). Untapped potentials of endophytic fungi: a review of novel bioactive compounds with biological applications. Microorganisms8:1934. doi: 10.3390/microorganisms8121934
60
Mao Z. Zhang W. Wu C. Feng H. Peng Y. Shahid H. et al . (2021). Diversity and antibacterial activity of fungal endophytes from Eucalyptus exserta. BMC Microbiol.21, 1–12. doi: 10.1186/s12866-021-02229-8
61
Marlatt M. L. Correll J. C. Kaufmann P. Cooper P. E. (1996). Two genetically distinct populations of Fusarium oxysporum f. sp. lycopersici race 3 in the United States. Plant. Dis.80, 1336–1342.
62
Marzoug H. N. B. Romdhane M. Lebrihi A. Mathieu F. Couderc F. Abderraba M. et al . (2011). Eucalyptus oleosa essential oils: chemical composition and antimicrobial and antioxidant activities of the oils from different plant parts (stems, leaves, flowers and fruits). Molecules16, 1695–1709. doi: 10.3390/molecules16021695
63
O'Donnell K. Cigelnik E. Nirenberg H. I. (1998). Molecular systematics and phylogeography of the Gibberella fujikuroi species complex. Mycologia90, 465–493. doi: 10.1080/00275514.1998.12026933
64
Onaga S. Taira T. (2008). A new type of plant chitinase containing LysM domains from a fern (Pteris ryukyuensis): roles of LysM domains in chitin binding and antifungal activity. Glycobiology18, 414–423. doi: 10.1093/glycob/cwn018
65
Panno S. Davino S. Caruso A. G. Bertacca S. Crnogorac A. Mandić A. et al . (2021). A review of the most common and economically important diseases that undermine the cultivation of tomato crop in the mediterranean basin. Agronomy11:2188. doi: 10.3390/agronomy11112188
66
Paris R. L. Mengistu A. Tyler J. M. Smith J. R. (2006). Registration of soybean germplasm line DT97-4290 with moderate resistance to charcoal rot. Crop Sci.46, 2324–2325. doi: 10.2135/cropsci2005.09.0297
67
Park Y. H. Mishra R. C. Yoon S. Kim H. Park C. Seo S. T. et al . (2019). Endophytic Trichoderma citrinoviride isolated from mountain-cultivated ginseng (Panax ginseng) has great potential as a biocontrol agent against ginseng pathogens. J. Ginseng Res.43, 408–420. doi: 10.1016/j.jgr.2018.03.002
68
Pedrero-Méndez A. Insuasti H. C. Neagu T. Illescas M. Rubio M. B. Monte E. et al . (2021). Why is the correct selection of Trichoderma strains important? The case of wheat endophytic strains of T. harzianum and T. simmonsii. J. Fungi7:1087. doi: 10.3390/jof7121087
69
Poveda J. (2021). Beneficial effects of microbial volatile organic compounds (MVOCs) in plants. Appl. Soil Ecol.168:104118. doi: 10.1016/j.apsoil.2021.104118
70
Prokhorov V. P. Linnik M. A. (2011). Morphological, cultural, and biodestructive peculiarities of Chaetomium species. Mosc. Univ. Biol. Sci. Bull.66, 95–101. doi: 10.3103/S0096392511030072
71
Rajani P. Rajasekaran C. Vasanthakumari M. M. Olsson S. B. Ravikanth G. Shaanker R. U. (2021). Inhibition of plant pathogenic fungi by endophytic Trichoderma spp. through mycoparasitism and volatile organic compounds. Microbiol. Res.242:126595. doi: 10.1016/j.micres.2020.126595
72
Regalado A. P. Pinheiro C. Vidal S. Chaves I. Ricardo C. P. Rodrigues-Pousada C. (2000). The Lupinus albus class-III chitinase gene, IF3, is constitutively expressed in vegetative organs and developing seeds. Planta210, 543–550. doi: 10.1007/s004250050043
73
Roy S. Banerjee D. (2019). “Volatile organic compounds from endophytic fungi” in Recent advancement in White biotechnology through Fungi: Volume 2: Perspective for value-added products and environments. eds. YadavA.SinghS.MishraS.GuptaA. (Cham, Switzerland: Springer), 149–175.
74
Saito H. Sasaki M. Nonaka Y. Tanaka J. Tokunaga T. Kato A. et al . (2021). Spray application of nonpathogenic fusaria onto rice flowers controls bakanae disease (caused by Fusarium fujikuroi) in the next plant generation. Appl. Environ. Microbiol.87, e01959–e01920. doi: 10.1128/AEM.01959-20
75
Samuels G. J. (2006). Trichoderma: systematics, the sexual state, and ecology. Phytopathology96, 195–206. doi: 10.1094/PHYTO-96-0195
76
Samuels G. J. Ismaiel A. Mulaw T. B. Szakacs G. Druzhinina I. S. Kubicek C. P. et al . (2012). The Longibrachiatum clade of Trichoderma: a revision with new species. Fungal Divers.55, 77–108. doi: 10.1007/s13225-012-0152-2
77
Santoyo G. Moreno-Hagelsieb G. del Carmen Orozco-Mosqueda M. Glick B. R. (2016). Plant growth-promoting bacterial endophytes. Microbiol. Res.183, 92–99. doi: 10.1016/j.micres.2015.11.008
78
Sharma A. Goyal A. K. (2017). Phosphate solubilizing microorganisms: a sustainable approach for improving soil fertility. IJCMAS.6, 3388–3395. doi: 10.17504/protocols.io.bhx8j7rw
79
Shirali A. (2017). Isolation and identification of fungi associated with melon crown and root rot disease in south east of Tehran. M.Sc thesis in Plant pathology, University of Tehran. Tehran, Iran.
80
Simmons E. G. (2007). Alternaria an identification manual. CBS biodiversity series, no. 6. CBS Fungal Biodiversity Centre, Utrecht: The Netherlands, 775.
81
Sivanesan A. (1987). Graminicolous species of Bipolaris, Curvularia, Drechslera, Exserohilum and their teleomorphs. Ferry Lane: CAB International Mycological Institute.
82
Sperber J. I. (1958). The incidence of apatite-solubilizing organisms in the rhizosphere and soil. Crop Pasture Sci.9, 778–781. doi: 10.1071/AR9580778
83
Steel R. G. Torrie J. H. (1980). Principles and procedures of statistics. New York: McGraw-Hill book co Inc, 481.
84
Strobel G. (2018). The emergence of endophytic microbes and their biological promise. J. Fungi4:57. doi: 10.3390/jof4020057
85
Strobel G. Daisy B. (2003). Bioprospecting for microbial endophytes and their natural products. Microbiol. Mol. Biol. Rev.67, 491–502. doi: 10.1128/MMBR.67.4.491-502.2003
86
Tadayyon Rad F. Ebrahimi L. (2023). Biocontrol of charcoal rot disease on tomato and melon using endophytic fungi in vitro and in vivo. Iranian J. Plant Protec. Sci.54, 1–17. doi: 10.22059/ijpps.2023.355691.1007022
87
Takeuchi M. Watanabe A. Tamura M. Tsutsumi Y. (2018). The gene expression analysis of Arabidopsis thaliana ABC transporters by real-time PCR for screening monolignol-transporter candidates. J. Wood Sci.64, 477–484. doi: 10.1007/s10086-018-1733-9
88
Thambugala K. M. Ariyawansa H. A. Li Y. M. Boonmee S. Hongsanan S. Tian Q. et al . (2014). Dothideales. Fungal Divers.68, 105–158. doi: 10.1007/s13225-014-0303-8
89
Thompson J. D. Higgins D. G. Gibson T. J. (1994). CLUSTAL W: improving the sensitivity of progressive multiple sequence alignment through sequence weighting, position-specific gap penalties and weight matrix choice. Nucleic Acids Res.22, 4673–4680. doi: 10.1093/nar/22.22.4673
90
Toghueo R. M. K. Ejiya I. E. Sahal D. Yazdani S. S. Boyom F. F. (2017). Production of cellulolytic enzymes by endophytic fungi isolated from Cameroonian medicinal plants. Int. J. Curr. Microbiol. App. Sci.6, 1264–1271. doi: 10.20546/ijcmas.2017.602.142
91
Verwoerd L. (1931). Descriptions of some new species of south African fungi and of species not previously recorded in South Africa-iii. S. Afr. J. Sci.28, 290–297.
92
Wani Z. A. Ashraf N. Mohiuddin T. Riyaz-Ul-Hassan S. (2015). Plant-endophyte symbiosis, an ecological perspective. Appl. Microbiol. Biotechnol.99, 2955–2965. doi: 10.1007/s00253-015-6487-3
93
Watanabe T. (2002). Pictorial atlas of soil and seed fungi: Morphologies of cultured fungi and key to species: CRC press.
94
Wei F. Zhang Y. Shi Y. Feng H. Zhao L. Feng Z. et al . (2019). Evaluation of the biocontrol potential of endophytic fungus Fusarium solani CEF559 against Verticillium dahliae in cotton plant. Biomed. Res. Int.2019, 1–12. doi: 10.1155/2019/3187943
95
Wenneker M. Thomma B. P. (2020). Latent postharvest pathogens of pome fruit and their management: from single measures to a systems intervention approach. Eur. J. Plant Pathol.156, 663–681. doi: 10.1007/s10658-020-01935-9
96
White T.J. Bruns T. Lee S.J.W.T. Taylor J. , (1990). Amplification and direct sequencing of fungal ribosomal RNA genes for phylogenetics. PCR protocols: a guide to methods and applications, 18, pp.315–322, Academic Press Inc., New York
97
Yadav L. S. Kushwaha V. Jain A. (2020). Isolation and screening of phosphate solubilizing fungi from okra rhizosphere soil and their effect on the growth of okra plant (Abelmoschous esculentus L.). Trop. Plant Res7, 277–284. doi: 10.22271/tpr.2020.v7.i2.033
98
Yan L. Zhu J. Zhao X. Shi J. Jiang C. Shao D. (2019). Beneficial effects of endophytic fungi colonization on plants. Appl. Microbiol. Biotechnol.103, 3327–3340. doi: 10.1007/s00253-019-09713-2
99
Zhang S. Xu B. Zhang J. Gan Y. (2018). Identification of the antifungal activity of Trichoderma longibrachiatum T6 and assessment of bioactive substances in controlling phytopathgens. Pestic. Biochem. Physiol.147, 59–66. doi: 10.1016/j.pestbp.2018.02.006
Summary
Keywords
antagonist, biocontrol, chitinase, cellulase, metabolites, volatile organic compounds
Citation
Aleahmad P, Ebrahimi L, Safaie N and Etebarian HR (2025) Antagonism of Eucalyptus endophytic fungi against some important crop fungal diseases. Front. Microbiol. 16:1523127. doi: 10.3389/fmicb.2025.1523127
Received
05 November 2024
Accepted
27 January 2025
Published
12 February 2025
Volume
16 - 2025
Edited by
Ravinder Kumar, Indian Agricultural Research Institute (ICAR), India
Reviewed by
Debdulal Banerjee, Vidyasagar University, India
Abdul Gafur, SMF Corporate R&D Advisory Board, Indonesia
Loekas-Soesanto, Jenderal Soedirman University, Indonesia
Hiran Kanti Santra, Vidyasagar University, India
Updates
Copyright
© 2025 Aleahmad, Ebrahimi, Safaie and Etebarian.
This is an open-access article distributed under the terms of the Creative Commons Attribution License (CC BY). The use, distribution or reproduction in other forums is permitted, provided the original author(s) and the copyright owner(s) are credited and that the original publication in this journal is cited, in accordance with accepted academic practice. No use, distribution or reproduction is permitted which does not comply with these terms.
*Correspondence: Leila Ebrahimi, Le_ebrahimi@ut.ac.ir
Disclaimer
All claims expressed in this article are solely those of the authors and do not necessarily represent those of their affiliated organizations, or those of the publisher, the editors and the reviewers. Any product that may be evaluated in this article or claim that may be made by its manufacturer is not guaranteed or endorsed by the publisher.